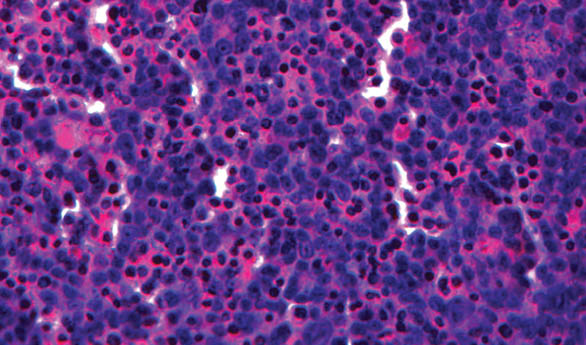

From musical instruments and race cars to weapons and art, almost anything can be made with a 3D printer. And although the technology has been around for a relative while (the first 3D printer was invented some 30 years ago and places like NASA and General Electric have been using 3D printing technology much like what Geomiq offers to the main-stream manufacturing market which allows them to make parts), the technology has only recently become widely available – and thus truly groundbreaking.
The range of materials that can be used is truly incredible, like acrylic, which can be easily bought from places like Simply Plastics.
Here’s a roundup of revolutionary inventions made possible by 3D printing. And we’re not just talking about a list of “five crazy things…” (1. sex toys, 2. pizza, 3. guns, 4. bikinis, 5. high heels), but a list of 3D printing innovations with the potential to move markets, disrupt industries and change the world.
1. Makeup

Harvard Business School grad and self-styled serial inventor Grace Choi debuted The Mink at TechCrunch Disrupt in New York City this week. The stylish and portable 3D printer is poised to potentially take down the entire makeup industry, calling cosmetic giants out on making “a whole lot of money on a whole lot of bulls—“.
“My initial target market, they’re girls, ages 13 to 21. They have not formed any habits yet and they’re still experimenting. And we’re gonna grow with them. And that’s how we’re gonna change how the world buys makeup,” Choi declared.
Like your friend’s lipstick? Take a picture and print your own. Like the shade of the sky in that video? Screenshot it and print the color in an eyeshadow.
Check out Choi’s demonstration of how The Mink works below:
2. Ocean Reefs

The world’s coral reefs are vanishing rapidly due to destructive human behavior like overfishing, pollution, coastal development and global warming. In Bahrain, coral cover has plummeted from over 50 percent in the 1980’s to almost zero today.
Enter Reef Arabia, an organization of local and international marine biologists that designs, manufactures and deploys 3D-printed reefs with the aim of replacing lost habitats and reviving disappearing fish populations.
The constructed reefs are made of non-toxic sandstone and features include wind towers, reef balls and structures that mimic Arab architecture. The 3D-printed sandstone attracts a greater diversity of sea life compared to other artificial reefs typically made from concrete.
“With 3D printing we can get closer to natural design because of its ability to produce very organic shapes and almost lay down material similar to how nature does it,” says Reef Arabia’s David Lennon.
See the 3D-printed sandstone reefs in action here:
3. Homes
With “Contour Crafting”, a process pioneered by Behrokh Khoshnevis, a professor of Industrial & Systems Engineering at the University of Southern California, a 2,320 square meter house complete with electricity and plumbing can be 3D printed in less than 20 hours.
An entire neighborhood – each house with a distinct blueprint – could be built in a month. The future of suburbia is upon us.

Impressive. But now imagine a more modest home and the application of Khoshnevis’s 3D printing process in slums and disaster areas. Could Contour Crafting be the future of development?
In this TEDx talk, Khoshnevis describes 3D printing “organic” structures similar to the one pictured here, a two-hundred-year-old adobe building still standing in one of the most earthquake-prone areas of Iran.
“The patterns that are used for building these are pretty ingenious. But those people are no longer accessible in a lot of places of the world and, if they are, they will be very expensive. However, with robotic systems we can mimic those patterns and build those beautiful structures automatically,” Khoshnevis says.
4. Living Cells

While we are still not at the stage where we’re 3D printing fully formed, implantable human organs, we’re well on our way.
Live ear and liver tissue are being 3D printed in research labs across the United States and China, with Chinese researchers printing live kidney tissue and American researchers printing a heart as well!
Meanwhile, a new process called Block-Cell-Printing ensures that almost all printed cells survive, a significant improvement compared to previously existing methods.
“Cell printing is used in so many different ways now – for drug development and in studies of tissue regeneration, cell function, and cell-cell communication,” Houston Methodist Research Institute’s Dr. Lidong Qin says.
“Such things can only be done when cells are alive and active. A survival rate of 50 to 80 percent is typical as cells exit the inkjet nozzles. By comparison, we are seeing close to 100 percent of cells in BloC-Printing survive the printing process.”
5. Prosthetics

What’s truly revolutionary about the 3D printing of human limbs is how you can DIY it for an insanely lower cost. Like Richard Van As, who lost four fingers in 2011 and was quoted $10,000 for a mechanical prosthetic. Instead, he 3D printed one at home.
But it doesn’t end there. Van As went one step further, applying his model to help others. The failed carpenter took his prototype, open sourced it and established Robohand, which provides 3D-printed prosthetics for deserving people around the world for as low as less than ten dollars.
Van Es also trained Mick Ebeling, co-founder and CEO of Not Impossible Labs, on how to construct a Robohand and Roboarm. Last year, Ebeling brought consumer-grade 3D printers to a hospital in war-torn Sudan and taught a team of locals how to produce artificial limbs that cost about $100 and take less than six hours to make.
Watch the inspiring video about Ebeling’s journey to Sudan below.
WE SAID THIS: Speaking of innovative uses for new technology, did you know that “Skype Weddings Are A Thing Now“?
